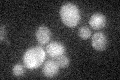
YBR258C
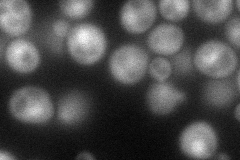
YBR258C
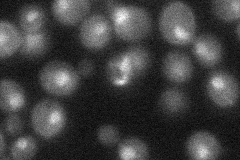
YBR258C
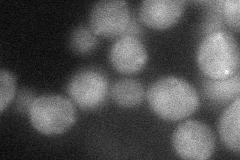
YBR258C
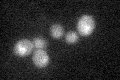
YBR258C

View description
Subunit of the COMPASS (Set1C) complex, which methylates histone H3 on lysine 4 and is required in transcriptional silencing near telomeres
Localization:
Intensity:
Fold change:
Significance:
-
C’ GFP library in SD
cytosol19.64 -
N' NOP1pr-GFP in SD
cytosol,nucleus72.9613 -
N' TEF2pr-mCherry in SD

cytosol37.4714 -
N' NATIVEpr-GFP in SD
nucleus32.0611 -
N' TEF2pr-VC and Cyto-VN in SD
cytosol40.4045 -
C’ GFP library in SD+DTT
cytosol18.280.93No -
C’ GFP library in SD+H2O2

cytosol16.890.85No -
C’ GFP library in Starvation Media

cytosol17.370.88No -
C’ GFP library on the background of Pup2-DaMP

cytosol -
C’ GFP library on the background of CCT mutant

cytosol17.63170.897084No
